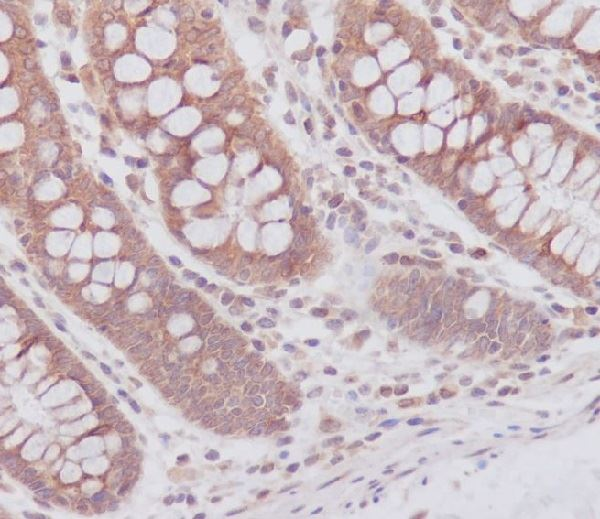
ATG7 Rabbit pAb 兔多克隆抗体

相关产品推荐更多 >
万千商家帮你免费找货
0 人在求购买到急需产品
- 详细信息
- 技术资料
- 供应商:
翌圣生物科技(上海)股份有限公司
- 库存:
现货
- 英文名:
ATG7 Rabbit pAb
- 保质期:
1年
- 保存条件:
-20度
- 规格:
50µl
产品信息
| 产品名称 |
产品编号 |
规格 |
价格(元) |
| ATG7 Rabbit pAb |
30073ES50 |
50 µL |
1285 |
| 30073ES60 |
100 µL |
1985 |
产品描述
该基因编码一种e1样激活酶,对细胞自噬和细胞质向液泡转运至关重要。 编码的蛋白质也被认为在长时间的代谢应激中调节p53依赖的细胞周期通路。 它与多种功能有关,包括轴突膜运输、轴突内稳态、线粒体吞噬、脂肪分化和造血干细胞维持。 选择性剪接导致多种转录变体。
产品性质

| 别名 |
ATG7; APG7-LIKE; APG7L; DKFZp434N0735; GSA7; |
| SwissProt ID |
O95352 |
| 基因ID |
10533 |
| 免疫原 |
A synthesized peptide derived from human ATG7 |
| 缓冲液 |
Rabbit IgG in phosphate buffered saline , pH 7.4, 150mM NaCl, 0.02% sodium azide and 50% glycerol. |
| 分子量 |
78kDa |
| 克隆类型 |
Polyclonal Antibody |
| 亚型 |
IgG |
| 宿主 |
Rabbit |
| 物种反应 |
Human |
| 纯化方式 |
Affinity Purified |
| 细胞定位 |
Cytoplasm,Preautophagosomal structure |
| 研究领域 |
内分泌代谢,细胞生物学与发育生物学 |
应用
稀释比WB: 1/10000-1/50000 IHC: 1/50-1/200 ICC/IF: 1/50-1/200 IP: 1/20 FC: 1/20
|
|
Western blot analysis of ATG7 expression in HepG2 cell lysate. |
![]() |
Immunohistochemical analysis of paraffin-embedded human colon, using ATG7 Antibody. |
运输与保存方法
冰袋运输。-20℃保存,1年有效期。
注意事项
1. 避免反复冻融。
2. 为了您的安全和健康,请穿实验服并戴一次性手套操作。
3. 本产品仅作科研用途!
产品数据
![]() |
Western blot analysis of ATG7 expression in HepG2 cell lysate. |
![]() |
Immunohistochemical analysis of paraffin-embedded human colon, using ATG7 Antibody. |
应用缩写
WB:蛋白质印迹法IHC-P:石蜡切片样本的免疫组织化学法IHC-F:冰冻切片样本的免疫组织化学法ICC/IF:免疫细胞荧光FC:流式细胞术 IP:免疫沉淀法ChIP:染色质免疫沉淀法ELISA:酶联免疫吸附测定,翌圣生物产品售后保障范围仅限官网产品详情页中“推荐应用”一栏写明的实验应用,请参照上方的缩写含义,仔细核对后选择合适的产品。
HB220607
风险提示:丁香通仅作为第三方平台,为商家信息发布提供平台空间。用户咨询产品时请注意保护个人信息及财产安全,合理判断,谨慎选购商品,商家和用户对交易行为负责。对于医疗器械类产品,请先查证核实企业经营资质和医疗器械产品注册证情况。